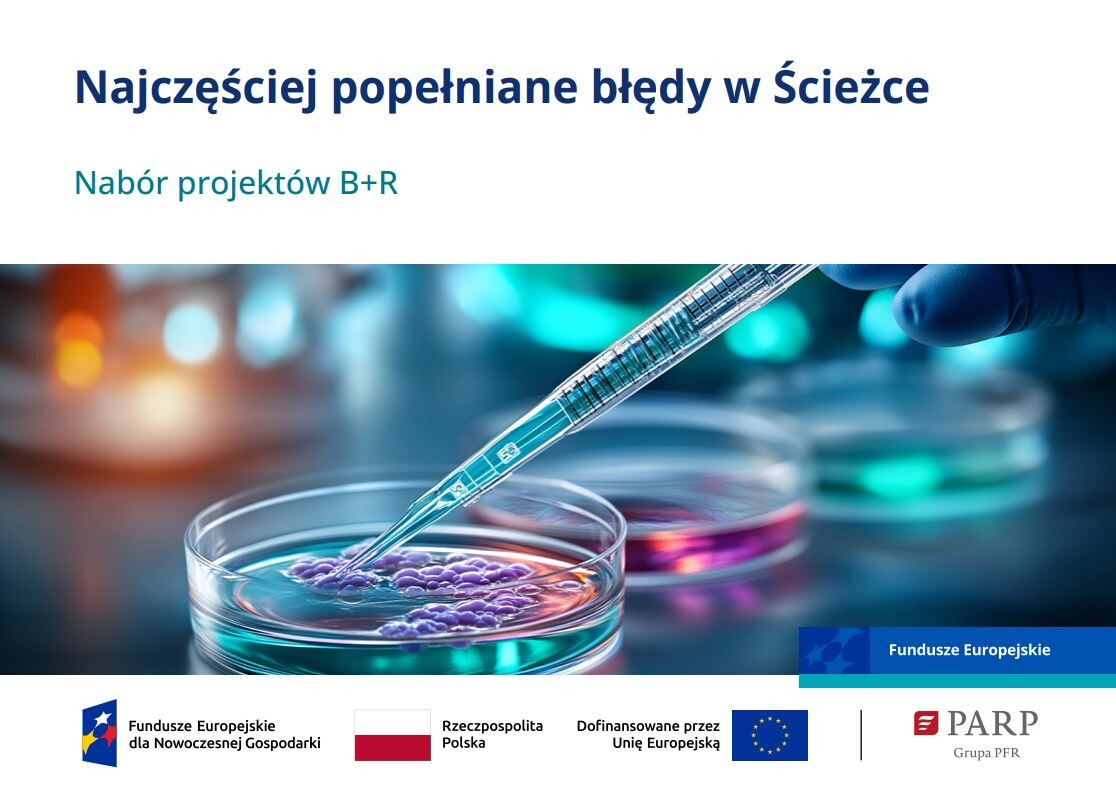
okładka publikacji

Udzielamy informacji o programach pomocowych realizowanych przez PARP.
Polska Agencja Rozwoju Przedsiębiorczości publikuje aktualizację listy ocenionych projektów w II etapie oceny w naborze FENG.01.01-IP.02-002/25 w działaniu Ścieżka SMART. Aktualizacja dotyczy jednego projektu skierowanego do II etapu oceny po uwzględnieniu protestu od negatywnej oceny w I etapie oraz trzech projektów, które w wyniku ponownej oceny zostały ocenione pozytywnie.
Listy projektów ocenionych pozytywnie i negatywnie po aktualizacji znajdują się w zakładce "Wyniki i archiwum" .
Ścieżka SMART – nabór projektów B+R
Zwiększenie zdolności badawczych i innowacyjnych przedsiębiorstw.
-
12 lutego 2026
Ogłoszenie konkursu
-
26 lutego 2026
Start składania wniosków
-
31 marca 2026
Koniec przyjmowania wniosków
Miejsce realizacji projektu
Polska
Zasięg terytorialny projektu
Polska i zagranica
Dla kogo
MŚP

Nabór został zakończony
Szczegóły dofinansowania
Szczegółowy opis
Rozwijanie i wzmacnianie zdolności badawczych i innowacyjnych oraz wykorzystywanie zaawansowanych technologii.
Dowiedz się więcej podczas cyklu warsztatów dla przedsiębiorców. Jak skutecznie zdobyć dofinansowanie na projekty B+R w Ścieżce SMART?
O dofinansowanie mogą ubiegać się wyłącznie mikro, mali i średni przedsiębiorcy prowadzący działalność gospodarczą na terytorium Rzeczypospolitej Polskiej.
Sprawdź, czy Twój projekt jest gotowy na Ścieżkę SMART? Przygotowanie dobrego wniosku o dofinansowanie to inwestycja wielu godzin pracy Twojego zespołu i często sporych środków finansowych. Zanim podejmiesz to ryzyko, zapoznaj się z pytaniami w krótkiej 7 punktowej ankiecie.
Innowacja co najmniej na poziomie krajowym.
Materiały szkoleniowe z poprzednich naborów do Ścieżki SMART
Nie masz pewności, czy to odpowiedni program finansowania dla twojej firmy?
Napisz lub zadzwoń na infolinię
Dokumenty
- Ogłoszenie o naborze
- Regulamin wyboru projektów
- Lista Krajowych Inteligentnych Specjalizacji
-
Przewodnik kwalifikowalności wydatków - obowiązuje od 26 marca 2026 r.
Załącznik nr 2 do Regulaminu wyboru projektów - Kryteria wyboru projektów
-
Słownik
Załącznik nr 6 do Regulaminu wyboru projektów - Pobierz wszystko
- Wzór wniosku o dofinansowanie projektu - obowiązuje od 26 lutego 2026 r.
-
Instrukcja wypełniania wniosku o dofinansowanie projektu - obowiązuje od 26 lutego 2026 r.
Zał. 8 do Regulaminu wyboru projektów - Model finansowy - obowiązuje od 18 maja 2026 r.
- Model finansowy - instrukcja - obowiązuje od 18 maja 2026 r.
- Upoważnienie do przekazania informacji objętych tajemnicą bankową
- Lista Obszarów Strategicznej Interwencji (OSI) - miast średnich tracących funkcje społeczno-gospodarcze
- Lista Obszarów Strategicznej Interwencji (OSI) - gmin zagrożonych trwałą marginalizacją
- Pobierz wszystko
-
Wzór umowy o dofinansowanie
Załącznik nr 4 do Regulaminu wyboru projektów
-
Szczegółowe warunki realizacji projektu
Załącznik nr 1 do Umowy -
Zestawienie wskaźników monitorowania projektu
Załącznik nr 4 do Umowy -
Wyciąg z zapisów Podręcznika w zakresie informacji i promocji
Załącznik nr 5 do Umowy -
Proponowane pomniejszenia
Załącznik nr 6 do Umowy - Pobierz wszystko
- Regulamin Pracy Komisji Oceny Projektów - Ścieżka Smart
- Załącznik nr 1 do RKOP: Wzór Oświadczenia eksperta o bezstronności, poufności i braku konfliktu interesów
- Załącznik nr 2 do Oświadczenia eksperta o bezstronności - Wykaz wniosków
- Załącznik nr 2 do RKOP: Wzór Oświadczenia pracownika o bezstronności, poufności i braku konfliktu interesów
- Załącznik nr 2 do Oświadczenia pracownika o bezstronności - Wykaz wniosków
- Załącznik nr 3 do RKOP: Wzór Deklaracji obserwatora o poufności
- Załącznik nr 4 do RKOP: Wzór arkuszy oceny projektu – etap I i II - obowiązuje od 12 maja 2026 r.
- Załącznik nr 1 do Protokołu z prac KOP - I etap oceny - Lista ocenionych projektów
- Załącznik nr 5.1 do RKOP: Wzór protokołu z prac Komisji Oceny Projektów - I etap - obowiązuje od 12 maja 2026 r.
- Załącznik nr 1 do Protokołu z prac KOP - II etap oceny - Lista ocenionych projektów
- Załącznik nr 5.2 do RKOP: Wzór protokołu z prac Komisji Oceny Projektów – II etap - obowiązuje od 12 maja 2026 r.
- Załącznik nr 1 do częściowego protokołu z prac KOP – II etap
- Załącznik nr 5.2a do RKOP: Wzór częściowego protokołu z prac KOP – II etap - obowiązuje od 12 maja 2026 r.
- Załącznik nr 6 do RKOP: Kryteria wyboru członków Komisji Oceny Projektów
- Załącznik nr 7 do RKOP: Szczegółowe zasady zlecania oceny projektów w ramach 1 Priorytetu FENG
- Załącznik nr 8.1 do RKOP: Wzór listy do publikacji na stronie internetowej – I etap
- Załącznik nr 8.2 do RKOP: Wzór listy do publikacji na stronie internetowej – II etap
- Załącznik nr 8.2a do RKOP: Wzór listy cząstkowej do publikacji na stronie internetowej – II etap
- Załącznik nr 9 do RKOP: Wzór wezwania do poprawy lub uzupełnienia wniosku
- Załącznik nr 10 do RKOP: Lista sprawdzająca wynik oceny projektu - Protokół z przebiegu oceny projektu - obowiązuje od 12 maja 2026 r.
- Pytania i odpowiedzi
- Pobierz wszystko
- Przewodnik kwalifikowalności wydatków - obowiązywał do 25 lutego 2026 r.
- Wzór wniosku o dofinansowanie projektu - obowiązywał do 25 lutego 2026 r.
- Instrukcja wypełniania wniosku o dofinansowanie projektu - obowiązywała do 25 lutego 2026 r.
- Model finansowy - obowiązywał do 25 lutego 2026 r.
- Model finansowy – instrukcja - obowiązywała do 25 lutego 2026 r.
- Przewodnik kwalifikowalności wydatków - obowiązywał do 25 marca 2026 r.
- Model finansowy - obowiązywał do 25 marca 2026 r.
- Model finansowy - instrukcja - obowiązywała do 25 marca 2026 r.
- Model finansowy - obowiązywał do 7 kwietnia 2026 r.
- Załącznik nr 4 do RKOP: Wzór arkuszy oceny projektu – etap I i II - obowiązywał do 11 maja 2026 r.
- Załącznik nr 5.1 do RKOP: Wzór protokołu z prac Komisji Oceny Projektów - I etap - obowiązywał do 11 maja 2026 r.
- Załącznik nr 5.2 do RKOP: Wzór protokołu z prac Komisji Oceny Projektów – II etap - obowiązywał do 11 maja 2026 r.
- Załącznik nr 5.2a do RKOP: Wzór częściowego protokołu z prac KOP – II etap - obowiązywał do 11 maja 2026 r.
- Załącznik nr 10 do RKOP: Lista sprawdzająca wynik oceny projektu - Protokół z przebiegu oceny projektu - obowiązywał do 11 maja 2026 r.
- Model finansowy - obowiązywał do 17 maja 2026 r.
- Model finansowy - instrukcja - obowiązywała do 17 maja 2026 r.
- Pobierz wszystko
FAQ
Nie ma bezwzględnego obowiązku składania Modelu finansowego w momencie wysyłania wniosku. Wnioskodawca może skorzystać z opcji złożenia Modelu finansowego oraz dokumentów potwierdzających finansowanie dopiero po zakwalifikowaniu się do II etapu oceny. W takim przypadku, po publikacji listy I etapu, wnioskodawca otrzyma informację o konieczności uzupełnienia tych dokumentów w systemie LSI w terminie 10 dni od dnia publikacji listy.
Nabór wniosków rozpoczyna się 26 lutego 2026 r. i trwa do 31 marca 2026 r. (do godziny 16:00 w ostatnim dniu naboru).
Nie, struktura modułowa została usunięta. W obecnym naborze nie ma już podziału na moduły (np. Cyfryzacja, Zazielenienie). Projekt musi obejmować obligatoryjny komponent badawczo-rozwojowy (prace B+R). Dodatkowe działania, takie jak umiędzynarodowienie, ochrona własności przemysłowej czy rozwój kompetencji, są realizowane jako zadania w ramach projektu, a nie jako odrębne moduły.
W przypadku umów kredytu lub pożyczki z banku, w których jednym z zabezpieczeń jest gwarancja de minimis BGK mogą wystąpić dwie sytuacje:
- umowa dotyczy finansowania wydatków niekwalifikowalnych w projekcie (np. podatku VAT) – wtedy taka umowa może zawierać zabezpieczenie w postaci gwarancji de minimis BGK;
- umowa dotyczy finansowania wydatków kwalifikowalnych w projekcie – wtedy zabezpieczenie w postaci gwarancji de minimis BGK może rodzić ryzyko przekroczenia limitów pomocy publicznej i de minimis na te same koszty. Pomocy publicznej, która jest udzielana na podstawie Rozporządzenia Komisji (UE) 651/2014, nie można kumulować z pomocą de minimis w odniesieniu do tych samych kosztów kwalifikowalnych, jeżeli skumulowana pomoc miałaby przekroczyć poziom intensywności pomocy, określony w rozdziale III ww. Rozporządzenia.
Jeśli podmiot dysponuje już taką zawartą z bankiem umową, w której to zabezpieczenie w postaci gwarancji de minimis BGK się znalazło, powinien:
- zwrócić się do banku o zmianę tej formy zabezpieczenia na inną i wyłączyć ją z umowy (zazwyczaj w formie aneksu) lub
- nie zmieniać umowy z bankiem, ale wtedy nie wnioskować do PARP o maksymalne możliwe dofinansowanie wynikające z limitów pomocy publicznej, lecz o dofinansowanie obniżone o wysokość udzielonej przez bank pomocy de minimis wynikającej z wydanego zaświadczenia o pomocy de minimis.
W sytuacji, jeśli na etapie oceny wniosku o dofinansowanie Wnioskodawca przedstawi promesę kredytową, a na etapie zawierania umowy o dofinansowanie z PARP – przedstawi właściwą umowę kredytową zawierającą jako zabezpieczenie spłaty kredytu gwarancję de minimis - konieczna będzie weryfikacja czy nie ma ryzyka przekroczenia limitów pomocy publicznej i pomocy de minimis na te same koszty. W przypadku wystąpienia ww. ryzyka, niezbędne będzie ponowne skierowanie projektu do oceny w zakresie zgodności projektu z limitami pomocy.
Nie zawsze. Jeżeli wkład własny jest finansowany ze środków własnych, dokumenty potwierdzające źródła finansowania mogą nie być wymagane. Wnioskodawca może jednak zostać wezwany po panelu KOP do przedstawienia dokumentów dot. jego sytuacji finansowej, jeśli z przebiegu panelu lub analizy Modelu finansowego wynikają informacje, które należy poprzeć stosownymi dokumentami. Wykaz wymaganych dokumentów wskazano w Instrukcji wypełniania Modelu finansowego (link: https://www.parp.gov.pl/storage/grants/documents/743/Instrukcja_Model_Finansowy_PARP_v3_16_fnl_1202026.pdf).
Po publikacji listy projektów zakwalifikowanych do II etapu wnioskodawca otrzymuje informację i ma 10 dni na dołączenie Modelu finansowego oraz – jeśli dotyczy – dokumentów potwierdzających źródła finansowania, poprzez odpowiednią funkcjonalność w LSI wskazaną w przesyłanej do niego mailowo informacji. Załączniki należy dodać w formacie zip. To bardzo ważne aby załączniki były załączone w formacie zip i we wskazanym terminie, ponieważ Model finansowy i dokumenty sporządzane w innym formacie i zamieszczone w LSI po terminie, nie będą brane pod uwagę w trakcie posiedzenia Panelu KOP.
Kwota przeznaczona na dofinansowanie projektów MŚP w naborze wynosi 700 000 000 zł (z możliwością zwiększenia na zasadach określonych w regulaminie).
Tak. Wniosek może obejmować również zadania dotyczące:
- umiędzynarodowienia (w tym promocji zagranicznej rezultatów),
- ochrony własności przemysłowej rezultatu projektu oraz obrony praw w przypadku naruszenia,
- zdobywania/rozwoju/doskonalenia kompetencji pracowników lub kadry zarządzającej – jako działania wspierające realizację projektu.
Projekt musi obejmować badania przemysłowe i eksperymentalne prace rozwojowe albo wyłącznie eksperymentalne prace rozwojowe. Warunkiem kwalifikowalności jest uwzględnienie co najmniej prac rozwojowych.
Wsparciem objęte są projekty o charakterze badawczo-rozwojowym, ukierunkowane na opracowanie innowacji produktowej lub innowacji w procesie biznesowym (w zakresie produkcji wyrobów lub usług). Rdzeniem projektu są prace B+R – to element obligatoryjny.
Polecane poradniki, raporty i katalogi
Inne dofinansowania, które mogą Cię zainteresować
Wyniki i archiwum
Dokumentacja
Start w konkursie
Poznaj cel i zakres konkursu oraz zasady wyboru i oceny projektów
- Ogłoszenie o naborze
-
Regulamin wyboru projektów
obowiązujący od 20.11.2025 -
Lista Krajowych Inteligentnych Specjalizacji
Zał. 1 do Regulaminu wyboru projektów -
Przewodnik kwalifikowalności wydatków
Zał. 2 do Regulaminu wyboru projektów - obowiązujący od 27.06.2025 -
Kryteria wyboru projektów Część I
Zał. 3 do Regulaminu wyboru projektów -
Kryteria wyboru projektów Część II
Zał. 3 do Regulaminu wyboru projektów -
Słownik
Zał. 6 do Regulaminu wyboru projektów
Składanie wniosku o dofinansowanie
Sprawdź jak wypełnić wniosek i jakie dołączyć dokumenty do wniosku
-
Wzór wniosku o dofinansowanie projektu
Zał. 7 do Regulaminu wyboru projektów – obowiązujący od 13.08.2025 -
Instrukcja wypełniania wniosku o dofinansowanie projektu
Zał. 8 do Regulaminu wyboru projektów - obowiązujący od 13.08.2025 -
Model finansowy
Zał. 5 do Regulaminu wyboru projektów -
Model finansowy – instrukcja
Zał. 5 do Regulaminu wyboru projektów – obowiązująca od 13.08.2025 -
Wzór upoważnienia do przekazania informacji objętych tajemnicą bankową
Zał. 5 do Regulaminu wyboru projektów – obowiązujący od 13.08.2025 -
Lista Obszarów Strategicznej Interwencji (OSI) - miast średnich tracących funkcje społeczno-gospodarcze
Zał. 9 do Regulaminu wyboru projektów -
Lista Obszarów Strategicznej Interwencji (OSI) - gmin zagrożonych trwałą marginalizacją
Zał. 10 do Regulaminu wyboru projektów
Podpisywanie umowy
Bądź przygotowany na podpisanie umowy, przeczytaj i wypełnij niezbędne dokumenty
-
Wzór umowy o dofinansowanie
Zał. 4 do Regulaminu wyboru projektów - obowiązujący od 27.06.2025
Załączniki do umowy
Załączniki
-
Szczegółowe warunki realizacji modułów
Zał. nr 1 do Umowy -
Zestawienie wskaźników monitorowania projektu
Zał. nr 4 do Umowy -
Wyciąg z zapisów Podręcznika w zakresie informacji i promocji
Zał. nr 5 do Umowy -
Proponowane pomniejszenia
Zał. nr 6 do Umowy
Dodatkowe dokumenty
Pozostałe dokumenty potrzebne do uzyskania dofinansowania
- Lista dokumentów do umowy - obowiązuje od 28.04.2026 r.
- Wniosek o dodanie osoby zarządzającej projektem
- Instrukcje użytkownika/Beneficjenta SL2021
- Oświadczenie Wnioskodawcy dotyczące aktualności danych
- Oświadczenie o wyrażeniu zgody na zaciągnięcie przez współmałżonka zobowiązania w postaci zawarcia umowy o dofinansowanie
- Oświadczenie o niepozostawaniu w związku małżeńskim
- Oświadczenie o prowadzeniu rachunku bankowego
- Oświadczenie o spełnianiu kryteriów MŚP
- Formularz informacji przedstawianych przy ubieganiu się o pomoc inną niż pomoc w rolnictwie lub rybołówstwie, pomoc de minimis lub pomoc de minimis w rolnictwie lub rybołówstwie
- Formularz informacji przedstawianych przy ubieganiu się o pomoc de minimis
- Oświadczenie o wysokości pomocy de minimis, de minimis w rolnictwie i rybołówstwie
- Formularz „Analiza zgodności projektu z polityką ochrony środowiska”
- Oświadczenie o sytuacji ekonomicznej
- Oświadczenie w związku z agresją Rosji wobec Ukrainy
- Oświadczenie dotyczące prowadzenia działalności na terenie Specjalnej Strefy Ekonomicznej
- Wzór karty pracy
- Zalecenia dotyczące prawidłowego wypełnienia weksla
- Wzór weksla
- Deklaracja wekslowa - osoby fizyczne
- Deklaracja wekslowa - osoby prawne
- Oświadczenie dotyczące kwalifikowalności podatku VAT
Dodatkowe dokumenty
Pozostałe dokumenty
- Regulamin Pracy Komisji Oceny Projektów – Ścieżka Smart – obowiązuje od 20.11.2025 r
- Załącznik nr 1 do RKOP: Wzór Oświadczenia eksperta o bezstronności, poufności i braku konfliktu interesów
- Załącznik nr 2 do Oświadczenia eksperta o bezstronności - Wykaz wniosków
- Załącznik nr 2 do RKOP: Wzór Oświadczenia pracownika o bezstronności, poufności i braku konfliktu interesów
- Załącznik nr 2 do Oświadczenia pracownika o bezstronności - Wykaz wniosków
- Załącznik nr 3 do RKOP: Wzór Deklaracji obserwatora o poufności
- Załącznik nr 4 do RKOP: Wzór arkuszy oceny projektu – etap I i II
- Załącznik nr 1 do Protokołu z prac KOP - I etap oceny - Lista ocenionych projektów
- Załącznik nr 5.1 do RKOP: Wzór protokołu z prac Komisji Oceny Projektów - I etap
- Załącznik nr 5.2a do RKOP: Wzór częściowego protokołu z prac Komisji Oceny Projektów – II etap
- Załącznik nr 1 do Protokołu częściowego z prac KOP - II etap oceny - Lista cząstkowa ocenionych projektów
-
Załącznik nr 1 do Protokołu z prac KOP - II etap oceny - Lista ocenionych projektów
obowiązuje od 20.11.2025 r - Załącznik nr 5.2 do RKOP: Wzór protokołu z prac Komisji Oceny Projektów – II etap
- Załącznik nr 6 do RKOP: Kryteria wyboru członków Komisji Oceny Projektów
- Załącznik nr 7 do RKOP: Szczegółowe zasady zlecania oceny projektów w ramach 1 Priorytetu FENG
- Załącznik nr 8.1 do RKOP: Wzór listy do publikacji na stronie internetowej – I etap
- Załącznik nr 8.2a do RKOP: Wzór listy cząstkowej do publikacji na stronie internetowej – II etap
-
Załącznik nr 8.2 do RKOP: Wzór listy do publikacji na stronie internetowej – II etap
obowiązuje od 20.11.2025 r. - Załącznik nr 2 do Protokołu z prac Komisji Oceny Projektów - Proces przydziału wniosków do oceny
- Pytania i odpowiedzi
Starsze wersje dokumentów
-
Regulamin wyboru projektów
Obowiązywał do 19.11.2025 -
Regulamin wyboru projektów
Obowiązywał do 12.08.2025 -
Regulamin wyboru projektów
Obowiązywał do 26.06.2025 -
Przewodnik kwalifikowalności wydatków
Obowiązywał do 26.06.2025 -
Instrukcja wypełniania wniosku o dofinansowanie projektu
Obowiązywała do 12.08.2025 -
Instrukcja wypełniania wniosku o dofinansowanie projektu
Obowiązywała do 26.06.2025 -
Wzór umowy o dofinansowanie
Obowiązywał do 26.06.2025 -
Wzór wniosku o dofinansowanie
Obowiązywał do 12.08.2025 -
Model finansowy - instrukcja
Obowiązująca do 12.08.2025 -
Model finansowy - instrukcja
obowiązująca do 24.04.2025 -
Regulamin Pracy Komisji Oceny Projektów - Ścieżka Smart
obowiązywał do 19.11.2025 -
Załącznik nr 8.2 do RKOP: Wzór listy do publikacji na stronie internetowej – II etap
obowiązywał do 19.11.2025 r. -
Załącznik nr 1 do Protokołu z prac KOP - II etap oceny - Lista ocenionych projektów
obowiązywał do 19.11.2025 r. - Lista dokumentów do umowy - obowiązywała do 27.04.2026 r.
List of projects
- Ścieżka Smart 2_2025- lista ocenionych projektów Etap I
- Ścieżka SMART 2_2025- Aktualizacja nr 1 listy ocenionych projektów Etap I
- Ścieżka SMART 2_2025- Aktualizacja nr 2 listy ocenionych projektów Etap I
- Ścieżka SMART 2_2025- lista ocenionych projektów Etap II- lista cząstkowa
- Ścieżka SMART 2_2025- lista ocenionych projektów Etap II
- Ścieżka SMART 2_2025- Aktualizacja nr 1 listy ocenionych projektów Etap II
- Ścieżka SMART 2_2025- Aktualizacja nr 2 listy ocenionych projektów Etap II
- Ścieżka SMART 2_2025- Aktualizacja nr 3 listy ocenionych projektów Etap II
- Ścieżka SMART 2_2025- Aktualizacja nr 4 listy ocenionych projektów Etap II
- Ścieżka SMART 2_2025- Aktualizacja nr 5 listy ocenionych projektów Etap II
- Ścieżka SMART 2_2025- Aktualizacja nr 6 listy ocenionych projektów Etap II
- Ścieżka SMART 2_2025- Aktualizacja nr 7 listy ocenionych projektów Etap II
- Ścieżka SMART 2_2025- Aktualizacja nr 8 listy ocenionych projektów Etap II
Composition of the project evaluation committee
Dokumentacja
Start w konkursie
Poznaj cel i zakres konkursu oraz zasady wyboru i oceny projektów
- Ogłoszenie o naborze
- Regulamin wyboru projektów - obowiązuje od 23.10.2024
-
Lista Krajowych Inteligentnych Specjalizacji
Zał. 1 do Regulaminu wyboru projektów -
Przewodnik kwalifikowalności wydatków
Zał. 2 do Regulaminu wyboru projektów -
Kryteria wyboru projektów Część I
Zał. 3 do Regulaminu wyboru projektów -
Kryteria wyboru projektów Część II
Zał. 3 do Regulaminu wyboru projektów -
Słownik
Zał. 6 do Regulaminu wyboru projektów
Składanie wniosku o dofinansowanie
Sprawdź jak wypełnić wniosek i jakie dołączyć dokumenty do wniosku
-
Wzór wniosku o dofinansowanie projektu
Zał. 7 do Regulaminu wyboru projektów -
Instrukcja wypełniania wniosku o dofinansowanie projektu - obowiązuje od 23.10.2024
Zał. 8 do Regulaminu wyboru projektów -
Model finansowy
Zał. 5 do Regulaminu wyboru projektów -
Model finansowy - instrukcja
Zał. 5 do Regulaminu wyboru projektów
Podpisywanie umowy
Bądź przygotowany na podpisanie umowy, przeczytaj i wypełnij niezbędne dokumenty
-
Wzór umowy o dofinansowanie - obowiązuje od 22.11.2024 r.
Zał. 4 do Regulaminu wyboru projektów
Załączniki do umowy
Załączniki
-
Szczegółowe warunki realizacji modułów
Zał. 1 do Umowy -
Zestawienie wskaźników monitorowania projektu
Zał. 4 do Umowy -
Wyciąg z zapisów Podręcznika w zakresie informacji i promocji - obowiązuje od 22.11.2024 r.
Zał. 5 do Umowy -
Proponowane pomniejszenia
Zał. 6 do Umowy
Dodatkowe dokumenty
Pozostałe dokumenty potrzebne do uzyskania dofinansowania
- Lista dokumentów niezbędnych do podpisania umowy o dofinansowanie
- Wniosek o dodanie osoby zarządzającej projektem
- Instrukcje użytkownika/Beneficjenta SL2021
- Oświadczenie Wnioskodawcy dotyczące aktualności danych
- Oświadczenie o wyrażeniu zgody na zaciągnięcie przez współmałżonka zobowiązania w postaci zawarcia umowy o dofinansowanie
- Oświadczenie o niepozostawaniu w związku małżeńskim
- Oświadczenie o prowadzeniu rachunku bankowego
- Oświadczenie o spełnianiu kryteriów MŚP
- Formularz informacji przedstawianych przy ubieganiu się o pomoc inną niż pomoc w rolnictwie lub rybołówstwie, pomoc de minimis lub pomoc de minimis w rolnictwie lub rybołówstwie
- Formularz informacji przedstawianych przy ubieganiu się o pomoc de minimis
- Oświadczenie o wysokości pomocy de minimis, de minimis w rolnictwie i rybołówstwie
- Formularz „Analiza zgodności projektu z polityką ochrony środowiska”
- Oświadczenie o sytuacji ekonomicznej
- Oświadczenie w związku z agresją Rosji wobec Ukrainy
- Oświadczenie dotyczące prowadzenia działalności na terenie Specjalnej Strefy Ekonomicznej
- Wzór karty pracy
- Zalecenia dotyczące prawidłowego wypełnienia weksla
- Wzór weksla
- Deklaracja wekslowa - osoby fizyczne
- Deklaracja wekslowa - osoby prawne
Dodatkowe dokumenty
Pozostałe dokumenty RKOP
- Regulamin Pracy Komisji Oceny Projektów - Ścieżka Smart
- Załącznik nr 1 do RKOP: Wzór Oświadczenia eksperta o bezstronności, poufności i braku konfliktu interesów
- Załącznik nr 2 do Oświadczenia eksperta o bezstronności - Wykaz wniosków
- Załącznik nr 2 do RKOP: Wzór Oświadczenia pracownika o bezstronności, poufności i braku konfliktu interesów
- Załącznik nr 2 do Oświadczenia pracownika o bezstronności - Wykaz wniosków
- Załącznik nr 3 do RKOP: Wzór Deklaracji obserwatora o poufności
- Załącznik nr 4 do RKOP: Wzór arkuszy oceny projektu – etap I i II
- Załącznik nr 1 do Protokołu z prac KOP - I etap oceny - Lista ocenionych projektów
- Załącznik nr 5.1 do RKOP: Wzór protokołu z prac Komisji Oceny Projektów - I etap
- Załącznik nr 1 do Protokołu z prac KOP - II etap oceny - Lista ocenionych projektów
- Załącznik nr 5.2 do RKOP: Wzór protokołu z prac Komisji Oceny Projektów – II etap
- Załącznik nr 6 do RKOP: Kryteria wyboru członków Komisji Oceny Projektów
- Załącznik nr 7 do RKOP: Szczegółowe zasady zlecania oceny projektów w ramach 1 Priorytetu FENG
- Załącznik nr 8.1 do RKOP: Wzór listy do publikacji na stronie internetowej – I etap
- Załącznik nr 8.2 do RKOP: Wzór listy do publikacji na stronie internetowej – II etap
- Załącznik nr 2 do Protokołu z prac Komisji Oceny Projektów - Proces przydziału wniosków do oceny
- Pytania i odpowiedzi
Materiały pomocnicze
Skorzystaj z dodatkowych informacji i narzędzi
Starsze wersje dokumentów
Dokumenty
- Regulamin wyboru projektów - obowiązujący do 22.10.2024 r.
-
Instrukcja wypełniania wniosku o dofinansowanie projektu - obowiązująca do 22.10.2023 r.
Zał. 8 do Regulaminu wyboru projektów -
Wzór umowy o dofinansowanie - obowiązywał do 21.11.2024 r.
Zał. 4 do Regulaminu wyboru projektów - Wyciąg z zapisów Podręcznika w zakresie informacji i promocji - obowiązywał do 21.11.2024 r.
List of projects
- Ścieżka SMART 1_2024 – lista ocenionych projektów, etap 1
- Ścieżka SMART 1_2024 – aktualizacja listy ocenionych projektów, etap 1
- Ścieżka SMART 1_2024 – lista ocenionych projektów, etap 2
- Ścieżka SMART 1_2024 – aktualizacja listy ocenionych projektów, etap 2
- Ścieżka SMART 1_2024 – aktualizacja nr 2 listy ocenionych projektów, etap 2
- Ścieżka SMART 1_2024 – aktualizacja nr 3 listy ocenionych projektów, etap 2
- Ścieżka SMART 1_2024 – aktualizacja nr 4 listy ocenionych projektów, etap 2
- Ścieżka SMART 1_2024 – aktualizacja nr 5 listy ocenionych projektów, etap 2
- Ścieżka SMART 1_2024 – aktualizacja nr 6 listy ocenionych projektów, etap 2
- Ścieżka SMART 1_2024 – aktualizacja nr 7 listy ocenionych projektów, etap 2
Composition of the project evaluation committee
Dokumentacja
Start w konkursie
Poznaj cel i zakres konkursu oraz zasady wyboru i oceny projektów
- Ogłoszenie o konkursie - obowiązuje od 20.10.2023
- Regulamin wyboru projektów - obowiązuje od 17.09.2024
-
Lista Krajowych Inteligentnych Specjalizacji
Zał. 1 do Regulaminu wyboru projektów -
Przewodnik kwalifikowalności wydatków - obowiązuje od 17.07.2024
Zał. 2 do Regulaminu wyboru projektów -
Kryteria wyboru projektów - wspólne i rankingujace
Zał. 3 do Regulaminu wyboru projektów -
Kryteria wyboru projektów - moduły - obowiązuje od 17.07.2024
Zał. 3 do Regulaminu wyboru projektów -
Słowniczek - obowiązuje od 20.10.2023
Zał. 6 do Regulaminu wyboru projektów
Składanie wniosku o dofinansowanie
Sprawdź jak wypełnić wniosek i jakie dołączyć dokumenty do wniosku
-
Wzór wniosku o dofinansowanie projektu - obowiązuje od 20.10.2023
Zał. 7 do Regulaminu wyboru projektów -
Instrukcja wypełniania wniosku o dofinansowanie projektu - obowiązuje od 20.10.2023
Zał. 8 do Regulaminu wyboru projektów -
Model finansowy - obowiązuje od 20.10.2023
Zał. 5 do Regulaminu wyboru projektów -
Model finansowy - instrukcja - obowiązuje od 20.10.2023
Zał. 5 do Regulaminu wyboru projektów
Podpisywanie umowy
Bądź przygotowany na podpisanie umowy, przeczytaj i wypełnij niezbędne dokumenty
-
Wzór umowy o dofinansowanie
Zał. 4 do Regulaminu wyboru projektów -
Wzór umowy o dofinansowanie - zmiana mechanizmu rozliczania zaliczek
Zał. 4 do Regulaminu wyboru projektów - Analiza zgodności projektu z polityką ochrony środowiska - obowiązuje od 31.10.2023
Załączniki do umowy
Załączniki
-
Szczegółowe warunki realizacji modułów - obowiązuje od 20.10.2023
Zał. 1 do Umowy -
Zestawienie wskaźników monitorowania projektu
Zał. 4 do Umowy -
Wyciąg z zapisów Podręcznika w zakresie informacji i promocji
Zał. 5 do Umowy -
Wyciąg z zapisów Podręcznika w zakresie informacji i promocji - obowiązuje od 7.11.2024 r.
Zał. 5 do Umowy -
Proponowane pomniejszenia
Zał. 6 do Umowy
Dodatkowe dokumenty
Pozostałe dokumenty potrzebne do uzyskania dofinansowania
- Lista dokumentów niezbędnych do zawarcia umowy
- Oświadczenie de minimis
- Oświadczenie o aktualności danych
- Oświadczenie o niepozostawaniu w związku małżeńskim
- Oświadczenie o prowadzeniu działalnosci w SSE
- Oświadczenie o prowadzeniu rachunku bankowego przeznaczonego do rozliczeń projektu
- Oświadczenie o sytuacji ekonomicznej
- Oświadczenie o spełnianiu kryteriów MŚP
- Oświadczenie współmałżonka - zgoda na zawarcie umowy
- Oświadczenie w związku z agresją Rosji wobec Ukrainy
- Formularz informacji przedstawianych przy ubieganiu się o pomoc de minimis
- Formularz informacji przedstawianych przy ubieganiu się o pomoc inną niż pomoc de minimis
- Wniosek o dodanie osoby zarządzającej projektem
- Instrukcje użytkownika SL2021
- Wzór karty pracy pracownika
- Deklaracja wekslowa - osoby fizyczne
- Deklaracja wekslowa - osoby prawne
- Wzór weksla in blanco
- Zalecenia dotyczące prawidłowego wypełniania weksla in blanco i deklaracji
- Pytania i odpowiedzi
Materiały pomocnicze
Skorzystaj z dodatkowych informacji i narzędzi
Starsze wersje dokumentów
- Regulamin wyboru projektów - obowiązywał od 17.07.2024 do 16.09.2024
- Regulamin wyboru projektów - obowiązywał od 16.04.2024 do 16.07.2024
- Regulamin wyboru projektów - obowiązywał do 15.04.2024
- Regulamin wyboru projektów - obowiązywał do 20.10.2023
- Regulamin wyboru projektów - obowiązujący do 8.05.2023
- Regulamin wyboru projektów - obowiązywał do 23.06.2023
-
Przewodnik kwalifikowalności wydatków - obowiązywał od 16.11.2023 do 16.07.2024
Zał. 2a do Regulaminu wyboru projektów -
Przewodnik kwalifikowalności wydatków - obowiązywał od 30.03.2023 do 15.11.2023
Zał. 2 do Regulaminu wyboru projektów -
Przewodnik kwalifikowalności wydatków - wersja z 20.10.2023 przed autokorektą
Zał. 2a do Regulaminu wyboru projektów - Ogłoszenie o konkursie - obowiązywał do 20.10.2023
- Ogłoszenie o konkursie - obowiązywało do 23.06.2023
- Analiza zgodności projektu z polityką ochrony środowiska - obowiązywał do 31.10.2023
-
Instrukcja wypełniania wniosku o dofinansowanie projektu - obowiązywał do 20.10.2023
Zał. 8 do Regulaminu wyboru projektów -
Wzór wniosku o dofinansowanie projektu - obowiązywał do 20.10.2023
Zał. 7 do Regulaminu wyboru projektów -
Szczegółowe warunki realizacji modułów - obowiązywał do 20.10.2023
Zał. 1 do Umowy -
Słowniczek - obowiązywał do 20.10.2023
Zał. 6 do Regulaminu wyboru projektów -
Wzór umowy o dofinansowanie - obowiązywał od 17.07.2024 do 16.09.2024
Zał. 4 do Regulaminu wyboru projektów -
Wzór umowy o dofinansowanie - obowiązywał od 20.10.2023 do 16.07.2024
Zał. 4 do Regulaminu wyboru projektów -
Wzór umowy o dofinansowanie - obowiązywał do 20.10.2023
Zał. 4 do Regulaminu wyboru projektów -
Wzór umowy o dofinansowanie - obowiązywał do 20.09.2023
Zał. 4 do Regulaminu wyboru projektów -
Wzór umowy o dofinansowanie - obowiązujący do 8.05.2023
Zał. 4 do Regulaminu wyboru projektów -
Model finansowy - obowiązywał do 20.10.2023
Zał. 5 do Regulaminu wyboru projektów - Model finansowy - obowiązywał do 20.09.2023
-
Model finansowy - obowiązujący do 16.08.2023
Zał. 5 do Regulaminu wyboru projektów -
Model finansowy - obowiązujący od 30.03 do 18.04.2023
Zał. 5 do Regulaminu wyboru projektów -
Model finansowy - instrukcja - obowiązywał do 20.10.2023
Zał. 5 do Regulaminu wyboru projektów - Model finansowy - instrukcja - obowiązywał do 20.09.2023
-
Model finansowy - instrukcja - obowiązujący do 16.08.2023
Zał. 5 do Regulaminu wyboru projektów -
Model finansowy - instrukcja - obowiązująca od 30.03 do 18.04.2023
Zał. 5 do Regulaminu wyboru projektów - Kryteria wyboru projektów - moduły - Zał. 3 do Regulaminu wyboru projektów - obowiązywały od 30.03.2023 do 15.11.2023
- Kryteria wyboru wyboru projektów - kryteria modułowe - Zał. 3a do Regulaminu wyboru projektów - obowiązywały od 16.11.2023 do 16.07.2024
List of projects
Ścieżka SMART nabór 2 2023 - lista ocenionych projektów - Aktualizacje
- Ścieżka SMART nabór 2 2023 – lista ocenionych projektów – Aktualizacja nr 5 - obowiązuje od 18.06.2025
- Ścieżka SMART nabór 2 2023 – lista ocenionych projektów – Aktualizacja nr 4 - obowiązuje od 28.04.2025
- Ścieżka SMART nabór 2 2023 – lista ocenionych projektów – Aktualizacja nr 3 - obowiązuje od 4.04.2025
- Ścieżka SMART nabór 2 2023 – lista ocenionych projektów – Aktualizacja nr 2 - obowiązuje od 28.02.2025
- Ścieżka SMART nabór 2 2023 – lista ocenionych projektów – Aktualizacja nr 1 - obowiązuje od 17.01.2025
Ścieżka SMART nabór 2 2023 – lista ocenionych projektów
Composition of the project evaluation committee
Dokumentacja
Start w konkursie
Poznaj cel i zakres konkursu oraz zasady wyboru i oceny projektów
- Ogłoszenie o konkursie - obowiązujące od 30.03.2023
- Regulamin wyboru projektów - obowiązuje od 29.09.2023
-
Lista Krajowych Inteligentnych Specjalizacji
Zał. 1 do Regulaminu wyboru projektów -
Przewodnik kwalifikowalności wydatków - obowiązuje od 6.04.2023
Zał. 2 do Regulaminu wyboru projektów -
Kryteria wyboru projektów - wspólne i rankingujace
Zał. 3 do Regulaminu wyboru projektów -
Kryteria wyboru projektów - moduły
Zał. 3 do Regulaminu wyboru projektów -
Słowniczek - obowiązuje od 29.09.2023
Zał. 6 do Regulaminu wyboru projektów
Składanie wniosku o dofinansowanie
Sprawdź jak wypełnić wniosek i jakie dołączyć dokumenty do wniosku
-
Wzór wniosku o dofinansowanie
Obowiązuje od 21.02.2023 r. - Instrukcja wypełniania wniosku o dofinansowanie projektu - obowiązuje od 6.04.2023
-
Model finansowy - obowiązuje od 18.04.2023
Zał. 5 do Regulaminu wyboru projektów -
Model finansowy - instrukcja - obowiązuje od 18.04.2023
Zał. 5 do Regulaminu wyboru projektów
Podpisywanie umowy
Bądź przygotowany na podpisanie umowy, przeczytaj i wypełnij niezbędne dokumenty
-
Wzór umowy o dofinansowanie
Zał. 4 do Regulaminu wyboru projektów -
Wzór umowy o dofinansowanie - zmiana mechanizmu rozliczania zaliczek
Zał. 4 do Regulaminu wyboru projektów - Wzór umowy o dofinansowanie – zmiana dla projektów uwzględniających pomoc de minimis – obowiązuje od 23.07.2024 r.
- Analiza zgodności projektu z polityką ochrony środowiska - obowiązuje od 31.10.2023
Załączniki do umowy
Załączniki
-
Szczegółowe warunki realizacji modułów
Zał. 1 do Umowy -
Zestawienie wskaźników monitorowania projektu
Zał. 4 do Umowy -
Wyciąg z zapisów Podręcznika w zakresie informacji i promocji
Zał. 5 do Umowy -
Wyciąg z zapisów Podręcznika w zakresie informacji i promocji - obowiązuje od 7.11.2024 r.
Zał. 5 do Umowy -
Proponowane pomniejszenia
Zał. 6 do Umowy
Dodatkowe dokumenty
Pozostałe dokumenty potrzebne do uzyskania dofinansowania.
- Wzór karty pracy pracownika
- Lista dokumentów niezbędnych do podpisania umowy o dofinansowanie - obowiązuje od 23.07.2024 r.
- Oświadczenie de minimis - obowiązuje od 23.07.2024 r.
- Oświadczenie o aktualności danych
- Oświadczenie o niepozostawaniu w związku małżeńskim
- Oświadczenie o prowadzeniu dzialności w SSE
- Oświadczenie o prowadzeniu rachunku bankowego przeznaczonego do rozliczeń projektu
- Oświadczenie o spełnianiu kryteriów MSP
- Oświadczenie o sytuacji ekonomicznej
- Oświadczenie w związku z agresją Rosji wobec Ukrainy
- Oświadczenie współmałżonka-zgoda na zawarcie umowy
- Wniosek o dodanie osoby zarządzającej projektem
- Instrukcja CST2021 dla beneficjentów
- Formularz informacji przedstawianych przy ubieganiu się o pomoc de minimis
- Formularz informacji przedstawianych przy ubieganiu się o pomoc inną niż pomoc w rolnictwie lub rybołówstwie, pomoc de minimis lub pomoc de minimis w rolnictwie lub rybołówstwie
- Wzór deklaracji wekslowej dla osób fizycznych
- Wzór deklaracji wekslowej dla osób prawnych
- Wzór weksla
- Zalecenia dotyczące prawidłowego wypełniania weksla in blanco i deklaracji
- Pytania i odpowiedzi
Materiały pomocnicze
Skorzystaj z dodatkowych informacji i narzędzi
-
Ścieżka oceny projektów w 1. naborze SMART
Skorzystaj z dodatkowych informacji i narzędzi - Kryteria SMART 1 - Lista sprawdzająca
- Analiza powodów negatywnej oceny - 1 nabór ścieżka SMART
Starsze wersje dokumentów
- Regulamin wyboru projektów - obowiązywał do 28.09.2023
- Regulamin wyboru projektów - obowiązywał od 30.03.2023 do 2.07.2023
- Regulamin naboru - obowiązujący do 30.03.2023
- Regulamin wyboru projektów - obowiązywał do 21.02.2023
- Ogłoszenie o naborze - obowiązujące do 30.03.2023
- Przewodnik kwalifikowalności wydatków - obowiązywał do 6.04.2023
-
Przewodnik kwalifikowalności wydatków - obowiązywał do 21.02.2023
Zał. 2 do Regulaminu wyboru projektów -
Przewodnik kwalifikowalności wydatków
Zał. 2 do Regulaminu wyboru projektów - Instrukcja wypełniania wniosku o dofinansowanie projektu - obowizująca do 6.04.2023
- Analiza zgodności projektu z polityką ochrony środowiska - obowiązywał do 31.10.2023
-
Wzór umowy o dofinansowanie - obowiązywał do 28.09.2023
Zał. 4 do Regulaminu wyboru projektów -
Wzór umowy o dofinansowanie - obowiązywał do 4.05.2023
Zał. 4 do Regulaminu wyboru projektów -
Wzór umowy o dofinansowanie - obowiązywał do 21.02.2023
Zał. 4 do Regulaminu wyboru projektów -
Słowniczek - obowiązywał do 28.09.2023
Zał. 6 do Regulaminu wyboru projektów -
Wzór wniosku o dofinansowanie
Obowiązywał do 20.02.2023 r. -
Model finansowy - obowiązywał od 30.03.2023 do 18.04.2023
Zał. 5 do Regulaminu wyboru projektów - Model finansowy - obowiązujący do 30.03.2023
-
Model finansowy - obowiązywał do 22.02.2023
Zał. 5 do Regulaminu wyboru projektów -
Model finansowy - instrukcja - obowiązuje od 30.03.2023 do 18.04.2023
Zał. 5 do Regulaminu wyboru projektów - Model finansowy - instrukcja obowiązująca do 30.03.2023
-
Model finansowy - instrukcja - obowiązywała do 22.02.2023
Zał. 5 do Regulaminu wyboru projektów - Lista dokumentów niezbędnych do podpisania umowy o dofinansowanie – obowiązywała do 22.07.2024
- Oświadczenie de minimis – obowiązywało do 22.07.2024
List of projects
Lista projektów – Aktualizacja nr 6
- Ścieżka SMART nabór 1 2023 projekty pozytywne – Aktualizacja nr 6
- Ścieżka SMART nabór 1 2023 projekty negatywne – Aktualizacja nr 6
Lista projektów – Aktualizacja nr 5
- Ścieżka SMART nabór 1 2023 projekty pozytywne – Aktualizacja nr 5
- Ścieżka SMART nabór 1 2023 projekty negatywne – Aktualizacja nr 5
Lista projektów – Aktualizacja nr 4
- Ścieżka SMART nabór 1 2023 projekty pozytywne – Aktualizacja nr 4
- Ścieżka SMART nabór 1 2023 projekty negatywne – Aktualizacja nr 4
Lista projektów – Aktualizacja nr 3
- Ścieżka SMART nabór 1 2023 projekty pozytywne – Aktualizacja nr 3
- Ścieżka SMART nabór 1 2023 projekty negatywne – Aktualizacja nr 3
Lista projektów – Aktualizacja nr 2
- Ścieżka SMART nabór 1 2023 projekty pozytywne – Aktualizacja nr 2
- Ścieżka SMART nabór 1 2023 projekty negatywne – Aktualizacja nr 2
Lista projektów – Aktualizacja nr 1
- Ścieżka SMART nabór 1 2023 projekty pozytywne – Aktualizacja nr 1
- Ścieżka SMART nabór 1 2023 projekty negatywne – Aktualizacja nr 1
Lista projektów
Composition of the project evaluation committee